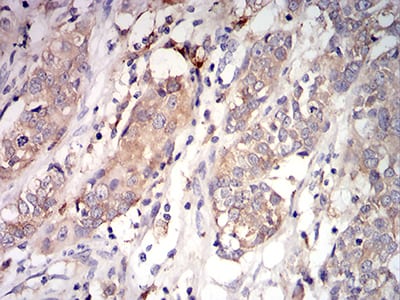

-
分类: 科研抗体货号: 31074别名: TDT应用: WB反应种属: Human
-
分类: 科研抗体货号: 31087别名: BUB1A; BUB1L; Hbub1应用: FCM反应种属: Human
-
分类: 科研抗体货号: 31101别名: MIB; DIP1; ZZZ6; DIP-1; LVNC7; ZZANK2应用: WB,FCM反应种属: Human,Monkey
-
分类: 科研抗体货号: 31086别名: PZF; DMS-8; DSM-8; FKSG11; ZFP-91; ZNF757应用: WB,IHC,IF,FCM反应种属: Human
-
分类: 科研抗体货号: 31100别名: MIB; DIP1; ZZZ6; DIP-1; LVNC7; ZZANK2应用: WB,IF,FCM反应种属: Human,Monkey
-
分类: 科研抗体货号: 31109别名:应用: IHC,FCM反应种属: Human
-
分类: 科研抗体货号: 31099别名: HGFR; AUTS9; RCCP2; c-Met; DFNB97应用: IF,FCM反应种属: Human
-
分类: 科研抗体货号: 31108别名:应用: IHC,FCM反应种属: Human
-
分类: 科研抗体货号: 31098别名: HGFR; AUTS9; RCCP2; c-Met; DFNB97应用: WB,IHC,IF,FCM反应种属: Human,Monkey
-
分类: 科研抗体货号: 31107别名: IDH; IDP; IDCD; IDPC; PICD; HEL-216; HEL-S-26应用: WB,IF,FCM反应种属: Human,Mouse,Monkey

鄂公网安备42018502007531号
鄂公网安备42018502007531号

